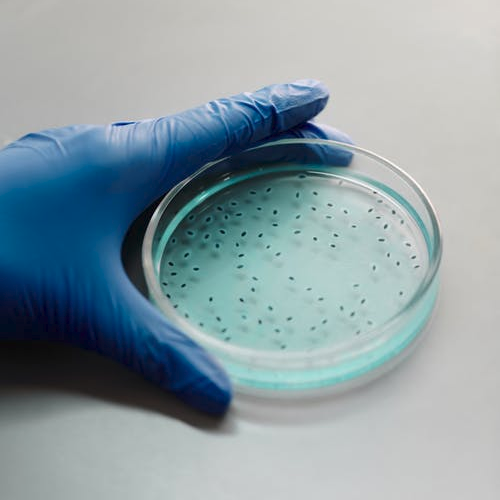

Controle de qualidade
A Avisa executa serviços de Ensaios Microbiológicos e Físico-químicos Ensaios Microbiológicos em Água Validação de Limpeza para Controle de Qualidade, tudo em laboratório próprio devidamente acreditados e habilitados.
Laboratórios acreditados e habilitados
Com instalações próprias e pessoal capacitado, os laboratórios da AVISA são habilitados pela ANVISA-REBLAS (Rede Brasileira de Laboratórios Analíticos em Saúde).

Atividades Desenvolvidas:

Ensaios microbiológicos em matérias primas, semi processados, semi acabados e granéis para verificação de conformidade;

Análises microbiológicas e físico-químicas da água para fabricação de produtos HPPC

Ensaios microbiológicos em processos de fabricação (validação da limpeza) - equipamentos, superfícies, colaboradores e do ar em ambientes produtivos da empresa;

Análises físico-químicas de conformidade dos produtos tendo como referência as especificações e metodologias aplicadas;
Análises microbiológicas para descartáveis (fraldas, absorventes, pad's, lenços umedecidos).

Análises microbiológicas requeridas para o produto acabado (RDC Nº 481/99);
Informações técnicas detalhadas
Ensaios Microbiológicos
Microbiologia Simples
Pesquisar, monitorar e controlar os microrganismos referentes à Resolução ANVISA n° 481, de 23 de setembro de 1999 em amostras de produtos de higiene pessoal,
perfumaria e cosméticos. Análises realizadas nesse ensaio:
- Contagem Total de Bactérias segundo ABNT NBR ISO 21149- Cosméticos-Microbiologia- Contagem e detecção de bactérias mesófilas aeróbicas-2008;
- Contagem de Bolores e Leveduras segundo ISO 16212- Cosmetics- Microbiology-Enumeration of yeast and mould-2008;
Microbiologia Completa
Pesquisar, monitorar e controlar os microrganismos referentes à Resolução ANVISA n° 481, de 23 de setembro de 1999 em amostras matérias primas e produtos de higiene pessoal, perfumaria e cosméticos. Análises realizadas nesse ensaio:
- Contagem Total de Bactérias segundo ABNT NBR ISO 21149- Cosméticos- Microbiologia- Contagem e detecção de bactérias mesófilas aeróbicas-2017;
- Contagem de Bolores e Leveduras segundo ISO 16212- Cosmetics- Microbiology- Enumeration of yeast and mould-2012;
- Pesquisa Bactérias Gram negativas Bile Tolerantes (Coliformes Totais) segundo Farmacopéia Brasileira 6ª Edição – 2019 Cap. 5.5.3.1.3;
- Pesquisa de Escherichia coli (Coliformes Fecais)segundo ABNT NBR ISO 21150- Cosméticos- Microbiologia- Detecção de Escherichia coli-2015;
- Pesquisa de Pseudomonas aeruginosa segundo ABNT NBR ISO 22717- Cosméticos- Microbiologia- Detecção de Pseudomonas aeruginosa-2015;
- Pesquisa de Staphylococcus aureus segundo ABNT NBR ISO 22718- Cosméticos- Microbiologia- Detecção de Staphylococcus aureus-2015.
Microbiologia em Produtos Descartáveis
As amostras são submetidas à contagem microbiológica a fim de pesquisar, monitorar e controlar possíveis microrganismos presentes no produto.
Os microrganismos analisados no teste referem-se à Resolução nº 142, de 17 de Março de 2017, sendo eles:
Os microrganismos analisados no teste referem-se à Resolução nº 142, de 17 de Março de 2017, sendo eles:
- Contagem de Microrganismos Aeróbios Mesófilos;
- Contagem de Fungos e Leveduras
- Pseudomonas aeruginosa;
- Staphylococcus aureus;
- Escherichia coli
- Candida albicans
Challenge Test (teste de desafio microbiano)
De acordo com Farmacopéia Brasileira 5ª Edição – 2010 Cap. 5.5.3.4 ou USP 37 cujo objetivo é a determinação da eficiência do sistema preservante em função do prazo de validade. Estudo dos 05 (cinco) microrganismos requeridos para produtos de higiene pessoal, perfumaria e cosméticos, sendo eles:
- Staphylococcus aureus;
- Pseudomonas aeruginosa;
- Escherichia coli;
- Aspergillus brasiliensis;
- Candida albicans.
Teste de Eficácia Antimicrobiana - Halo de Inibição
Determinar a sensibilidade de microrganismos patogênicos a antimicrobianos.
Estudo de 04 (quatro) microrganismos, sendo eles:
Estudo de 04 (quatro) microrganismos, sendo eles:
- Escherichia coli;
- Staphylococcus aureus;
- Pseudomonas aeruginosa;
- Salmonella sp.;
Time Kill (Avaliação Reducional da População Microbiana)
Ensaio que a redução populacional dos microrganismos para avaliação da atividade antimicrobiana de produtos antissépticos e/ou desinfetantes conforme CEN, I.S. EN-1040-2006 (phase 1).
Os microrganismos requeridos para esse ensaio serão sempre de origem Gram positiva e Gram negativa:
Os microrganismos requeridos para esse ensaio serão sempre de origem Gram positiva e Gram negativa:
- Sthapylococcus aureus – ATCC 6538
- Staphylococcus epidermidis – ATCC 12228
- Tricophyton mentagrophytes – ATCC 9533
- Tricophyton rubrum – ATCC 28188
- Corynebacterium xerosis – ATCC 373
Microbiologia em Água Purificada
Contagem total de bactérias mesófilas aeróbias, pesquisa de Coliformes Totais e Fecais e Pseudomonas aeruginosa.
Parâmetros segundo Farmacopéia Brasileira 5ª Edição-2010, Guia ABC de Microbiologia - Associação Brasileira de Cosmetologia (Água Purificada para Indústria Cosmética) - 2014. Guia de Microbiologia- ABHIPEC-2015
Parâmetros segundo Farmacopéia Brasileira 5ª Edição-2010, Guia ABC de Microbiologia - Associação Brasileira de Cosmetologia (Água Purificada para Indústria Cosmética) - 2014. Guia de Microbiologia- ABHIPEC-2015
Microbiologia em Água Potável
Contagem total de bactérias mesófilas aeróbias, pesquisa de Coliformes Totais e Fecais (Escherichia coli).
Parâmetros segundo Portaria nº 2914- Ministério da Saúde- Padrão de Potabilidade e segundo Farmacopéia Brasileira 5ª Edição-2010
Parâmetros segundo Portaria nº 2914- Ministério da Saúde- Padrão de Potabilidade e segundo Farmacopéia Brasileira 5ª Edição-2010
Microbiologia em Ar
Pesquisar, monitorar e controlar superfícies, equipamentos, utensílios e/ou quaisquer outras fontes de possível colonização, multiplicação e disseminação de bactérias e fungos a fim de se conseguir garantir o controle de qualidade desejado. Parâmetros segundo o Guia de Microbiologia ABC - 2014 e Guia de Microbiologia ABIHPEC-2015
Swab em superfícies, equipamentos e embalagens
Pesquisar, monitorar e controlar superfícies, equipamentos, utensílios e/ou quaisquer outras fontes de possível colonização, multiplicação e disseminação de bactérias e fungos a fim de se conseguir garantir o controle de qualidade desejado. Parâmetros segundo o Guia de Microbiologia ABC -2014 e Guia de Microbiologia ABIHPEC-2015
Ensaios Físicos-químicos
Estabilidade Acelerada (24 meses)
Os testes de estabilidade microbiológica, organoléptica e físico-química a serem realizados nos produtos, referem-se a:
Teste de estabilidade acelerada (90 dias), em 4 temperaturas (estufa 45 ºC +/- 2,5ºC; geladeira 5 ºC +/- 3ºC; ambiente 22,5 ºC +/- 2,5ºC e radiação solar) avaliando a performance do produto, compreendendo análises organolépticas (cor, odor, aspecto), físico-químicas (pH, densidade e viscosidade) e microbiológicas dos produtos em embalagem pretendida.
Objetivo: determinar o prazo de validade de 24 meses, utilizando referências normativas ABNT’s, ISO, Farmacopéia Brasileira e Guia de Estabilidade - ANVISA.
Teste de estabilidade acelerada (90 dias), em 4 temperaturas (estufa 45 ºC +/- 2,5ºC; geladeira 5 ºC +/- 3ºC; ambiente 22,5 ºC +/- 2,5ºC e radiação solar) avaliando a performance do produto, compreendendo análises organolépticas (cor, odor, aspecto), físico-químicas (pH, densidade e viscosidade) e microbiológicas dos produtos em embalagem pretendida.
Objetivo: determinar o prazo de validade de 24 meses, utilizando referências normativas ABNT’s, ISO, Farmacopéia Brasileira e Guia de Estabilidade - ANVISA.
Estudo de Compatibilidade de Produto X Embalagem
Teste de compatibilidade – produto x embalagem – em 5 condições (temperatura baixa 5ºC, temperatura ambiente 22,5ºC ±2,5°C, temperatura elevada 50ºC e 45°C e radiação solar) por 08 semanas.
Análises Físico-Químicas
- Características organolépticas (aspecto, cor e odor) de acordo Guia de Controle de Qualidade da ANVISA;
- Análise de pH de acordo com a Farmacopéia Brasileira 5ª Edição - 2010;
- Análise de densidade de acordo com a Farmacopéia Brasileira 5ª Edição - 2010;
- Análise de viscosidade de acordo com a Farmacopéia Brasileira 5ª Edição – 2010.
Galeria de fotos:
Peça um orçamento
A Avisa está a disposição para consultas, seja qual for o porte da sua empresa.







